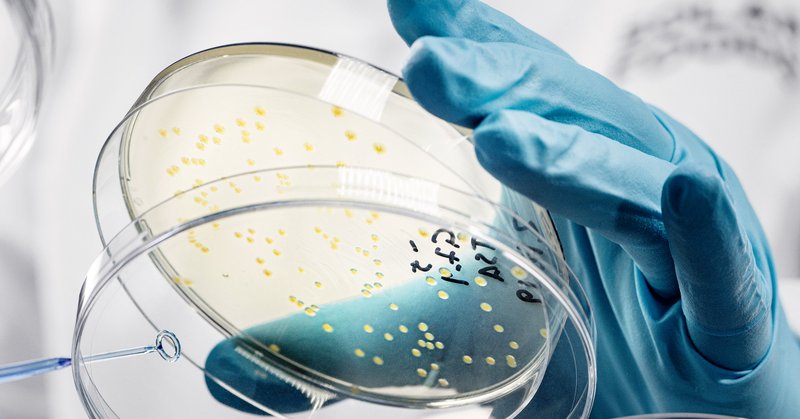
Tweet card summary image

Tutkitusti.
@tutkitusti
Followers
2K
Following
7K
Media
569
Statuses
4K
Tutkittua tietoa ajankohtaisista aiheista huolella kuratoidusti. Tutkitusti-verkosto kattaa miltei 20 suomenkielistä populaaria tiedejulkaisua.
Helsinki, Finland
Joined February 2017
Ekokriisin edellyttämä kestävyysmurros vaikuttaa väistämättä myös tulevaisuuden työelämään. Eeva Houtbeckers, Timo Räikkönen ja Suvi Salmenniemi kirjoittavat tutkimuksestaan, jossa on tarkasteltu kestävyystyön käytäntöjä työpaikoilla.
ilmiomedia.fi
Ekokriisin edellyttämä kestävyysmurros vaikuttaa väistämättä myös tulevaisuuden työelämään. Tutkimuksemme mukaan kestävyyteen pyrkiminen aiheuttaa jännitteitä työpaikkojen arjessa.
0
1
4
"Humoristisille näkymille nauraessa voimme päätellä monenlaisia asioita itsestämme ja tavastamme katsoa maailmaa. Samoin huumorikuvastoa tarkastellessa on mahdollista päätellä, mitä nykyään pidetään naurettavana." Jarno Hietalahti, Hybris
hybrislehti.net
0
0
0
"Stand-up komiikan antropologinen tutkimus kertoo paljon paitsi yksilöiden huumorintajusta, myös siitä, miksi individualistinen minäkäsitys on tärkeä osa stand-up komiikan kulttuurista kontekstia." Marianna Keisalo @antroblogi
antroblogi.fi
Stand-up -komiikan ristiriitaisuudet heijastavat yksilöllisen minäkäsityksen ristiriitoja: stand-up on yksilölaji, mutta vaatii toimiakseen yleisön.
1
0
0
"Komiikka voi ottaa kantaa: se voi paljastaa ja kritisoida valtarakenteita eikä vain tukea niitä tai toimia niiden varjossa." Marianna Keisalo ja Heikki Multanen @antroblogi
antroblogi.fi
Miten komedia ja valta liittyvät toisiinsa? Miten valta rakentuu stand-up tilanteessa, ja miten vitsi heijastelee valta-asetelmia?
1
0
0
Viikon #huumori-teemapaketissa pohditaan huumorin ja vallan suhdetta. Siinä, missä huumori on henkilökohtainen kokemus, on nauraminen sosiaalista ja komiikasta löydettävissä myös oma väkivaltainen puolensa.
1
0
1
“Esimerkiksi ilmastoon tai ravintoon ja terveyteen liittyvät kysymykset näyttäytyvät melko faktaperusteisina, kun taas esimerkiksi ruoan identiteettiin liittyvien merkitysten kohdalla myös mielipiteille annetaan arvoa.” Marianna Keisalo @antroblogi 👇
antroblogi.fi
Antropologi Marianna Keisalo toteutti katsauksen suomalaisen ruuan käsittelystä mediassa Food and Future Forumin tilauksesta.
1
1
0
“Monet kokivat erityisen tärkeäksi kehittää solumaatalouden ympärille sellaista sanastoa, joka herättää kuluttajakansalaisissa myönteisiä ja luonnollisia mielleyhtymiä.” Emilia Laine @IlmioMedia 👇 https://t.co/D4oUQW5uVH
ilmiomedia.fi
Solumaatalous pyrkii ratkaisemaan ruokajärjestelmän ongelmia tuottamalla bioteknologian avulla ”ruokaa ilman peltoja”. Laajemmassa kuvassa nämä odotukset tulisi kuitenkin ymmärtää poliittisina...
1
0
0
“valinnanmahdollisuudet asettavat kuluttajat eriarvoiseen asemaan, valinnoilla erottaudutaan ja erilaiset resurssit painottuvat vaihtelevasti erilaisissa ruoalla viestittävissä elämäntavoissa.” Taru Lindblom @IlmioMedia 👇
ilmiomedia.fi
Millainen ruoka sinulle maistuu? Entä koetko joskus paineita syödä tai juoda jotain, minkä makua inhoat? Luokka-asema on monin tavoin yhteydessä siihen, miten syömme – ja miten ajattelemme, että...
1
0
0
🔎 Tällä viikolla teimme haun sanalla #ruoka. Ruoka ja siihen liittyvät suositukset ja odotukset puhututtavat. Sitä, millaista ruokaa todellisuudessa syömme ja tulemme tulevaisuudessa syömään ohjaavat kuitenkin monet asiat, kuten media, uudet teknologiat ja sosiaalinen luokka.
1
0
0
Onko Trumpin suosio ei-valkoisten keskuudessa todella merkki rasismin hiipumisesta Yhdysvalloissa? Lue Martta Kaskisen uutiskommentti osoitteessa https://t.co/qYbG8BWcEX
0
1
2
Kehittäjäopettaja-hankkeen ensimmäinen vuosi on päättymässä, kiitos rahoituksesta @wihurinrahasto. Vuodessa on rakennettu oppimateriaalipankki, luotu oppimateriaalia ja näitä testattu opettajien kanssa hyvin tuloksin. Lisää tutkittua tietoa opetukseen!
0
1
1
”Nuorten päihderiippuvuuteen liittyviä ilmiöitä tarkastellaan ennen kaikkea nykyhetkessä sekä haittoja vähentävän työn näkökulmasta. Moni kuitenkin putoaa lapsuuden turvaverkkojen läpi jo varhain, usein ennen päihdeongelmaa”, kirjoittaa Keiju Vihreäsalo.
ilmiomedia.fi
Nuorten päihderiippuvuuteen liittyviä ilmiöitä tarkastellaan ennen kaikkea nykyhetkessä sekä haittoja vähentävän työn näkökulmasta. Moni kuitenkin putoaa lapsuuden turvaverkkojen läpi jo varhain,...
0
2
4
"Huumorilla on monia merkityksiä ja vaikutuksia. Sen kautta voi rakentaa yhteisöllisyyttä tai hyökätä. Vitsi voi välittää piiloviestejä tai kuvata tilannetta, jolle on vaikea löytää järkevää selitystä, tai edes sanoja." Marianna Keisalo @antroblogi
antroblogi.fi
Koronahuumori on globaalin pandemian mukanaan tuoma ilmiö, joka on vallannut etenkin sosiaalisen median. Miksi koronavitsit naurattavat?
0
0
0
"Huumori lieventää raskaiden asioiden ympärillä kihisevää painetta tuomalla synkät asiat valoon, jossa niille voidaan yhdessä hetken aikaa nauraa." Ninnu Koskenalho @antroblogi
antroblogi.fi
Raskas ja vaarallinen työ vaatii tuekseen kieroa huumoria. Tähän tulokseen tuli suomalaisia ydinjätteen parissa työskenteleviä ammattilaisia tutkinut antropologi, jonka yhdeksi tutkimuskohteeksi...
1
0
0
"Huumoriin usein liitetystä kepeydestä ja epävakavuudesta huolimatta nauru ei halvenna tuskaa, vaan muistuttaa inhimillisyydestä, toivosta ja siitä, kuinka vajavaisia olentoja ihmiset ovatkaan." Jarno Hietalahti @Politiikasta_fi
politiikasta.fi
Ukrainalaiset kokoontuvat sodan keskellä nauramaan stand up -klubeille. Huumori muistuttaa tarpeettoman kuoleman ja tuhon mielettömyydestä, mutta samalla myös toivosta.
1
0
0
Joulukuun #huumori-teemapaketeissa pohditaan komiikan ja naurun kulttuurisia ja yhteiskunnallisia taajuuksia. Kuinka nauraa asioille, joissa ei ole mitään hauskaa?
1
0
0
“Naisten kunniaa oli suojeltava, mutta siveellisyyskysymys antoi myös hyvän suojan ajaa kaikille, eritoten miehille, tärkeitä palkkaus- ja työaikakysymyksiä.” Tuula Vuolle-Selki Hybris 👇
hybrislehti.net
1
0
0
“Suomalaisessa kansanperinteessä pappi nähtiin perinteisesti esikuvana, jonka takissa ”fläkit pian näkyivät”. Siihen kuvaan eivät sopineet pyrkimykset pappien omien etujen ajamisesta saati lakkojen kaltaiset mielenilmaukset.“ Esko M. Laine @teologiafi 👇
teologia.fi
Kirkossa otettiin käyttöön virkaehtosopimusjärjestelmä yhteiskunnan viimeisenä vanhan maailman saarekkeena vuonna 1975. Se antoi papistolle ensimmäisen kerran lakko-oikeuden. Muutos oli radikaali,...
1
0
0